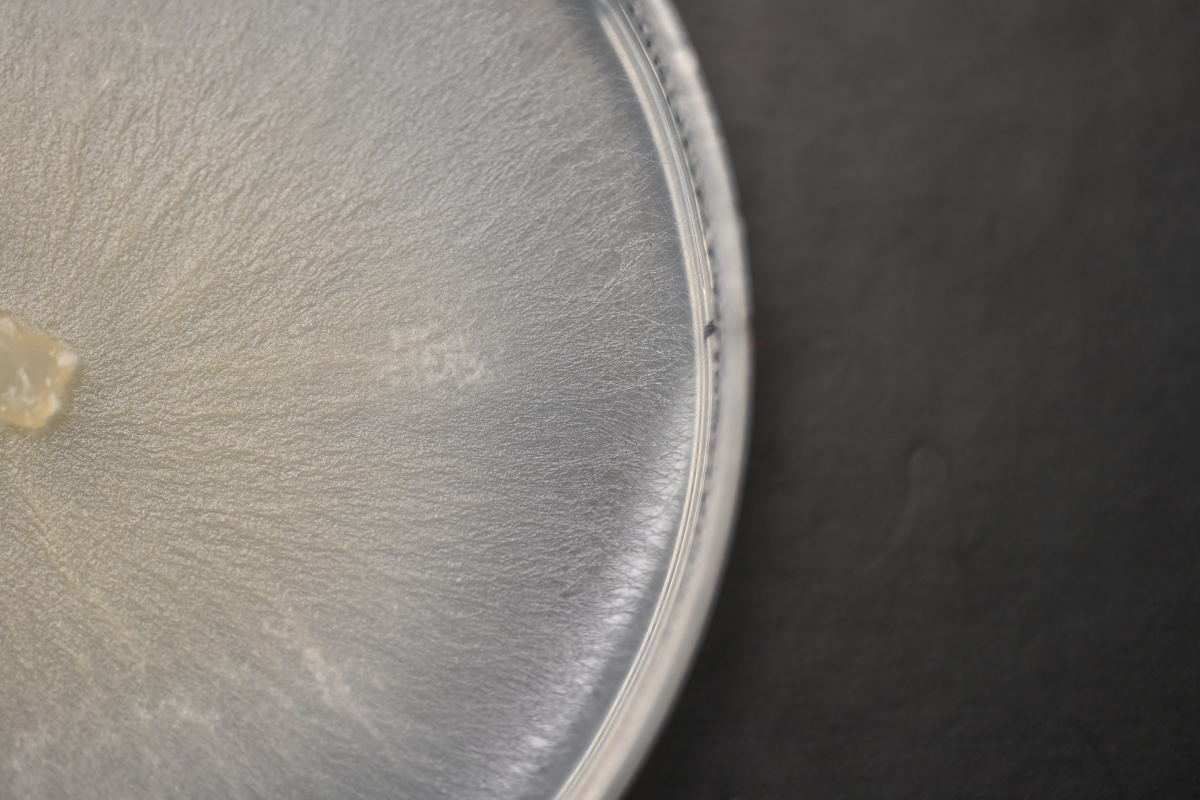
A close up of a petri dish growing white fungus

Western Australia is home to an extraordinary diversity of terrestrial orchids. This is in part due to our variety of landscapes, many isolated and nutrient poor, which give rise to an explosive evolutionary radiation in the orchid family. The unique floral forms range from the outrageous sunset hues of the iconic Queen of Sheba to the more beguiling and warty shapes of the hammer orchids.
Each floral offering serves to entice a particular suite of pollinators to ensure the next generation of orchids is sustained. Below-ground, terrestrial orchids form partnerships with mycorrhizal fungi that are necessary for germination of the world’s tiniest seeds. These partnerships are reformed each year as both plant and fungus awaken from summer dormancy. It is no wonder that in one of the largest plant families, with so many intricate ecosystem interactions, that we also see a disproportionately high number of rare species. There are 44 species of orchids listed as Threatened in Western Australia and a further 79 of Priority conservation concern. The level of threat faced by Western Australia’s orchids is particularly alarming when we consider that 95 per cent of species are found nowhere else in the world.
ORCHID CONSERVATION
Kings Park Science has been at the forefront of orchid research and conservation for the past 30 years with a long running and successful Orchid Conservation Program. The aim is to address the complex conservation challenges faced by our unique orchid flora.
The threats facing orchids are shared by many species and include land clearing, impacting both plants and pollinators; small and fragmented populations; changes to hydrology; an increasingly drying climate and changed rainfall patterns; and more recently, for some species an increasing interest and visitation by wildflower enthusiasts.
The first line of defence against extinction is in collections safely stored away for the future. These collections are ex situ, which means organisms are conserved and studied outside of their natural environment. Unlike most other plants, orchid collections require paired biological material with both the orchid seed and the fungal partner required for each orchid species. Orchid translocations to the wild will not be successful without introducing plant and fungus together.
Mycorrhizal fungi are collected from orchid tissue, isolated and cultured at Kings Park’s laboratories and tested for efficacy (ability to germinate seed) before storage. Both seed and fungi are stored cryogenically for the long term in liquid nitrogen. This collection is the only long term, orchid conservation ex situ collection in Western Australia, providing genuine insurance against extinction risk for the most critically endangered species.
A comprehensive approach to capturing the genetic and geographic breadth of a species, from all populations, is applied when creating a collection. Orchids must be visited during flowering to hand pollinate plants as seed set is naturally low. This pollination also allows for the parentage of the seed to be tracked – a vital factor of an ex situ collection. Tracking parentage ensures the genetic integrity of a collection and accordingly, the potential end use of boosting wild numbers. Visits to populations also provide important insight into threatening processes and species ecology, alongside opportunities to update species numbers and uncover unknown populations, all of which directly supports and informs on-ground management.
Recent efforts have targeted the poorly represented arid species of the Midwest, South West and Swan regions. Kings Park now holds 11 species with comprehensive collections that can be called upon for translocation efforts if required.
In recent years, staff from the Department of Biodiversity, Conservation and Attractions' (DBCA) Blackwood District of the South West region reached out over concerns for Bussell’s Spider Orchid (Caladenia busselliana), whose wild population numbers had plummeted from a few hundred in the 1990s to just four individual plants. Collections of seed and fungi from the remaining plants were quickly carried out, and intensive propagation efforts shortly followed, with a captive population of over 2000 seedlings now thriving in the Kings Park glasshouses.
Some of the plants generated were from seed collected in 1999 from a population that no longer exists, highlighting just how important ex situ collections are to conservation.
Over four years, three translocations were established bringing the wild number from four, up to 776 plants. In the last two years we have seen these populations produce seed capsules naturally and observed the first recruitment of seedlings achieving the ultimate translocation goal of self-sustainability. This successful translocation process is now being applied to other orchids in the Blackwood District including Lodge’s Spider Orchid (Caladenia lodgeana) and the Dunsborough Spider Orchid (Caladenia viridescens).
THE LIVING COLLECTION AT KINGS PARK
Alongside the cryogenically stored collection, Kings Park Science also houses the State’s only ex situ living collection of orchids. It is a dynamic collection from which seed and pollen can be harvested for storage or used for cross pollination with wild plants. The living collection is also used for education purposes and research, providing a supply of flowers that can be used for pollinator research without impacting wild populations. Species such as Pterostylis sinuata (Northampton Greenhood), which had never been successfully germinated before, now form a part of the ex situ living collection.
Some orchids present unique challenges in their conservation journey and require development of new protocols. Kings Park Science’s world-class facilities including incubators with temperature and light-controlled conditions and a dedicated tissue culture room allow for fine tuning these protocols for very special species.
A particular achievement for the Kings Park Science team has been overcoming the difficulties in isolation and storage of Thelymitra variegata (Queen of Sheba) seed and mycorrhizal fungi. Recent work has been focused on improving the output and vigour of seedlings from the limited seed sources available for this ultra rare plant. It is expected that tissue culture improvements will offer conservation solutions for a range of more challenging orchid species.
COLLABORATIONS AND PROGRAMS
Networking is not just for the orchids; the Orchid Conservation Program also fosters relationships in the research and conservation space. From Friends of Kings Park volunteers dedicating their time and expertise to collection maintenance and propagation, to DBCA volunteers helping scientists collect data in the field. Collaborations with the Australian Seed Bank Partnership and World Wide Fund for Nature have breathed life into the translocation of Caladenia busselliana through the Rare Bloom Project and ambitious ex situ collections through the Critically Endangered Project. Kings Park has strong collaborative ties to the Royal Botanic Gardens Victoria orchid conservation program, working in and publishing conservation research together.
The Saving Native Species Program, a Commonwealth Government initiative to support the recovery of threatened plants, animals and ecosystems is supporting the Orchid Conservation Program to provide in situ and ex situ conservation actions for five of our most threatened orchids. Conservation activities will include fencing, weed management, population surveys and ex situ collections of all populations encompassing both seed and fungi serving as insurance populations against population decline. The species being assisted by this program are Caladenia granitora (South Coast), Calochilus pruinosus (South Coast), Thelymitra variegata (Swan and South West), Diuris eburnea (Midwest) and Rhizanthella johnstonii (South Coast).
Looking forward, Kings Park Science is embarking on a flagship program, Saving Native Orchids for the Future. The program goal is to make ex situ collections for all 44 threatened orchid species before wild populations disappear forever. Kings Park Science is actively seeking out partnerships and securing funding for this 10-year program. With 10 per cent of the State’s orchid flora listed as Threatened, it is a race against the clock to provide conservation solutions for our precious orchid species. With Kings Park Science’s recent conservation success in self-sustaining translocations, prioritised and secure ex situ collections and research supporting on ground management, there is certainly good cause to be optimistic.
Find out more about how you can support the program at www.bgpa.wa.gov.au/collaborate
Complete collections and their regions
South West Region
- Caladenia busselliana
- Caladenia viridescens
- Caladenia lodgeana
- Caladenia procera
Midwest Region
- Caladenia elegans
- Caladenia hoffmanii
- Caladenia bryceana subsp. cracens
- Drakaea concolor
- Pterostylis sinuata
- Caladenia barbarella
Swan Region
- Caladenia hopperiana